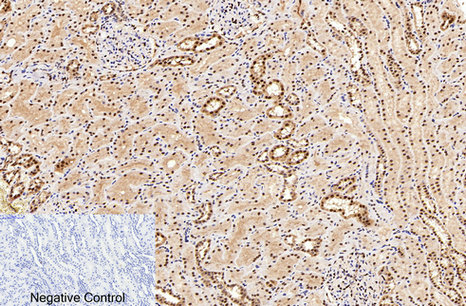

|
※サムネイル画像をクリックすると拡大画像が表示されます。
Immunofluorescence analysis of Human-breast-cancer tissue. 1,Caspase-7 Polyclonal Antibody(red) was diluted at 1:200(4°C,overnight). 2, Cy3 labled Secondary antibody was diluted at 1:300(room temperature, 50min).3, Picture B: DAPI(blue) 10min. Picture A:Target. Picture B: DAPI. Picture C: merge of A+B

Immunofluorescence analysis of Human-breast-cancer tissue. 1,Caspase-7 Polyclonal Antibody(red) was diluted at 1:200(4°C,overnight). 2, Cy3 labled Secondary antibody was diluted at 1:300(room temperature, 50min).3, Picture B: DAPI(blue) 10min. Picture A:Target. Picture B: DAPI. Picture C: merge of A+B

Immunofluorescence analysis of Human-liver-cancer tissue. 1,Caspase-7 Polyclonal Antibody(red) was diluted at 1:200(4°C,overnight). 2, Cy3 labled Secondary antibody was diluted at 1:300(room temperature, 50min).3, Picture B: DAPI(blue) 10min. Picture A:Target. Picture B: DAPI. Picture C: merge of A+B

Immunofluorescence analysis of Human-liver-cancer tissue. 1,Caspase-7 Polyclonal Antibody(red) was diluted at 1:200(4°C,overnight). 2, Cy3 labled Secondary antibody was diluted at 1:300(room temperature, 50min).3, Picture B: DAPI(blue) 10min. Picture A:Target. Picture B: DAPI. Picture C: merge of A+B

Immunofluorescence analysis of Human-lung tissue. 1,Caspase-7 Polyclonal Antibody(red) was diluted at 1:200(4°C,overnight). 2, Cy3 labled Secondary antibody was diluted at 1:300(room temperature, 50min).3, Picture B: DAPI(blue) 10min. Picture A:Target. Picture B: DAPI. Picture C: merge of A+B

Immunofluorescence analysis of Human-lung tissue. 1,Caspase-7 Polyclonal Antibody(red) was diluted at 1:200(4°C,overnight). 2, Cy3 labled Secondary antibody was diluted at 1:300(room temperature, 50min).3, Picture B: DAPI(blue) 10min. Picture A:Target. Picture B: DAPI. Picture C: merge of A+B

Immunohistochemical analysis of paraffin-embedded Human-breast tissue. 1,Caspase-7 Polyclonal Antibody was diluted at 1:200(4°C,overnight). 2, Sodium citrate pH 6.0 was used for antibody retrieval(>98°C,20min). 3,Secondary antibody was diluted at 1:200(room tempeRature, 30min). Negative control was used by secondary antibody only.

Immunohistochemical analysis of paraffin-embedded Human-breast-cancer tissue. 1,Caspase-7 Polyclonal Antibody was diluted at 1:200(4°C,overnight). 2, Sodium citrate pH 6.0 was used for antibody retrieval(>98°C,20min). 3,Secondary antibody was diluted at 1:200(room tempeRature, 30min). Negative control was used by secondary antibody only.

Immunohistochemical analysis of paraffin-embedded Human-kidney tissue. 1,Caspase-7 Polyclonal Antibody was diluted at 1:200(4°C,overnight). 2, Sodium citrate pH 6.0 was used for antibody retrieval(>98°C,20min). 3,Secondary antibody was diluted at 1:200(room tempeRature, 30min). Negative control was used by secondary antibody only.

Immunohistochemical analysis of paraffin-embedded Human-liver tissue. 1,Caspase-7 Polyclonal Antibody was diluted at 1:200(4°C,overnight). 2, Sodium citrate pH 6.0 was used for antibody retrieval(>98°C,20min). 3,Secondary antibody was diluted at 1:200(room tempeRature, 30min). Negative control was used by secondary antibody only.

|

|
|
Immunofluorescence analysis of Human-breast-cancer tissue. 1,Caspase-7 Polyclonal Antibody(red) was diluted at 1:200(4°C,overnight). 2, Cy3 labled Secondary antibody was diluted at 1:300(room temperature, 50min).3, Picture B: DAPI(blue) 10min. Picture A:Target. Picture B: DAPI. Picture C: merge of A+B
|
|
| 交差種 |
Human
Mouse
Rat
|
| 適用 |
Western Blot
IHC paraffin embedding section
Enzyme Linked Immunosorbent Assay
Immuno Fluorescence
Immunocytochemistry (cell)
|
| 精製度 |
Affinity Purified
|
| Accession No.(Gene/Protein) |
P55210
|
|
| メーカー |
品番 |
包装 |
|
ASY
|
L0164
|
50 UL
|
※表示価格について
| 当社在庫 |
なし
|
| 納期目安 |
2週間程度
|
| 保存温度 |
-20℃
|
|